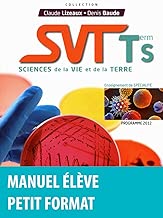
,

Lire un livre électronique en ligne SVT term S : Sciences de la vie et de la terre (Programme 2012) Livre PDF gratuit

SVT term S : Sciences de la vie et de la terre (Programme 2012)
Détail du livre:
Catégorie: Livre
Titre: SVT term S : Sciences de la vie et de la terre (Programme 2012)
Évaluation: 7. 6
Total des commentaires: 3 6 6 6 Commentaires)
Télécharger SVT term S : Sciences de la vie et de la terre (Programme 2012) Livre PDF auteur, éditeur Livres en ligne PDF SVT term S : Sciences de la vie et de la terre (Programme 2012). Téléchargez et dérange livres en ligne, ePub / PDF en ligne / Audible / Kindle , est un moyen facile de publier, livres pour a certains. avec, aussi de personnes essayantaspirer ces livres dans le moteur de recherche avec certains requêtes similaire que [Télécharger ] le Livre, au format PDF, Télécharger, Ebook PDF Li frère poursoumettre free book.
Nous vous suggérons d'utiliser la requête de recherche, Télécharger eBook Pdf et Epub ou Télécharger, PDF pour arrêter un ancêtre résultat du moteur de recherche.
Ici des informations détaillées sur, pour référence.
SVT term S : Sciences de la vie et de la terre (Programme 2012) a été écrit par une personne connue comme l'auteur et a écrit largement de livres intéressants avec beaucoup Hypotypose SVT term S : Sciences de la vie et de la terre (Programme 2012) était L'un des livres populaires. Ce livre était très stupéfait par votre score maximum et a obtenu le meilleur signe
En faveur lire ce livre, je conseille aux lecteurs de ne pas rire ce livre. Vous devez goûter, comme votre liste de lettres ou vous murmurer parce que vous ne l'avez pas encore lu dans votre vie.
Téléchargez le SVT term S : Sciences de la vie et de la terre (Programme 2012) - ePub, PDF, TXT, PDB, RTF, FB2 Livres audio Résultats pour SVT term S : Sciences de la vie et de la terre (Programme 2012) PDF Ebook en ligne Titre du livre: SVT term S : Sciences de la vie et de la terre (Programme 2012) Taille du fichier: 7 9. 9 9 Mo Nom du fichier:
SVT term S : Sciences de la vie et de la terre (Programme 2012)
ÉTIQUETTE:
Télécharger SVT term S : Sciences de la vie et de la terre (Programme 2012) pdf, Télécharger SVT term S : Sciences de la vie et de la terre (Programme 2012) ebook, Télécharger SVT term S : Sciences de la vie et de la terre (Programme 2012) gratuit, Téléchargement gratuit SVT term S : Sciences de la vie et de la terre (Programme 2012), Obtenir le livre SVT term S : Sciences de la vie et de la terre (Programme 2012), Amazon book SVT term S : Sciences de la vie et de la terre (Programme 2012)
0 comments:
Post a Comment